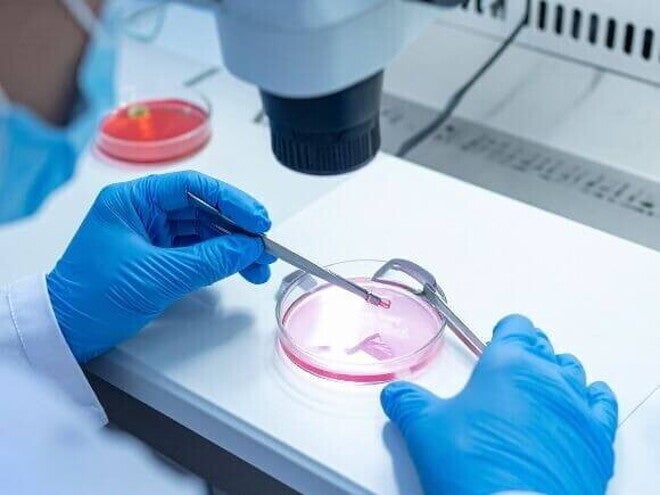
Imagem de laboratório onde um embriologista, usando luvas cirúrgicas, manipula material biológico em uma placa de Petri sob um microscópio, parte do processo de criopreservação de óvulos.

Congelamento de óvulos: tudo o que você precisa saber para planejar sua maternidade
Pensar em maternidade é um sonho lindo, mas cada mulher tem seu tempo para vivê-lo. Se você está considerando planejar a gravidez para o futuro, o congelamento de óvulos pode ser uma grande aliada nessa jornada.
O congelamento de óvulos, também conhecido como criopreservação, é uma técnica de reprodução assistida que permite às mulheres preservar sua fertilidade para o futuro.
Seja por motivos pessoais, profissionais ou médicos, essa opção oferece a possibilidade de planejar a maternidade no momento mais adequado. Quer entender melhor sobre o assunto?
Aqui, vamos explicar de forma simples e clara como funciona o congelamento de óvulos, quem pode se beneficiar e quais são as etapas desse processo. Além disso, você vai entender os cuidados e as chances de sucesso. Confira a seguir!
O que é o congelamento de óvulos e como funciona essa técnica?
O congelamento de óvulos é um processo que envolve a coleta e o armazenamento dos óvulos em temperaturas extremamente baixas, utilizando nitrogênio líquido.
O objetivo é preservar a qualidade dos óvulos para uso futuro em procedimentos de fertilização in vitro (FIV). O congelamento de óvulos é uma técnica moderna de reprodução assistida que ajuda a preservar a fertilidade da mulher para o futuro.
O congelamento acontece por meio de um método chamado vitrificação, que conserva os óvulos em nitrogênio líquido a temperaturas muito baixas (-196ºC), garantindo que eles possam ser armazenados por tempo indeterminado sem perder qualidade.
Quando a mulher decidir que é o momento certo para engravidar, os óvulos são descongelados, fertilizados em laboratório e os embriões resultantes são transferidos para o útero.
Essa técnica oferece uma chance segura e promissora para adiar a maternidade com confiança, cheia de cuidado e respeito pelo seu corpo e seus planos.
Quem pode se beneficiar do congelamento de óvulos?
O congelamento de óvulos é uma opção valiosa para muitas mulheres que desejam preservar a fertilidade e planejar a maternidade no momento que for mais adequado para elas.
Essa técnica é especialmente indicada para quem deseja adiar a gravidez por motivos pessoais, profissionais ou de saúde, como o início de tratamentos médicos que podem afetar os ovários, como quimioterapia e radioterapia para câncer.
Mulheres com condições que comprometem a fertilidade, como endometriose, lúpus ou baixa reserva ovariana, também podem se beneficiar desse recurso.
Embora o congelamento possa ser feito em diferentes idades, os especialistas recomendam que seja feito preferencialmente antes dos 35 anos, porque a qualidade dos óvulos diminui com o passar do tempo.
Mulheres que estão em fase de transição na vida, sem parceiro definido, ou que querem garantir mais segurança nas possibilidades de gravidez futura, encontram no congelamento de óvulos uma forma de cuidar do seu corpo e dos seus sonhos com mais tranquilidade.
Essa técnica é uma aliada para quem quer preservar a qualidade genética dos óvulos e aumentar as chances de uma gestação saudável quando decidir que chegou a hora da maternidade.
Quais são as principais razões para optar pelo congelamento de óvulos?
Diversos fatores podem levar uma mulher a considerar o congelamento de óvulos:
- Adiamento da maternidade: por motivos profissionais, educacionais ou pessoais;
- Tratamentos médicos: como quimioterapia ou radioterapia, que podem afetar a fertilidade;
- Condições de saúde: como endometriose ou doenças autoimunes;
- Ausência de parceiro: para mulheres que desejam ser mães no futuro, mas ainda não têm um parceiro.
Como é realizado o processo de congelamento de óvulos?
O processo envolve várias etapas:
- Estimulação ovariana: uso de hormônios para estimular os ovários a produzirem múltiplos óvulos;
- Monitoramento: acompanhamento por ultrassonografias e exames hormonais;
- Coleta dos óvulos: realizada por punção transvaginal, sob sedação;
- Congelamento: os óvulos maduros são congelados por vitrificação e armazenados em nitrogênio líquido.
Primeiro, há uma avaliação clínica, onde são feitos exames de sangue e ultrassom para entender como está a saúde da mulher e sua reserva ovariana.
Depois, inicia-se a estimulação ovariana, que dura cerca de 10 a 15 dias, com hormônios que ajudam os ovários a produzirem vários óvulos maduros ao invés de um só, como acontece naturalmente.
Quando os óvulos estão prontos, eles são coletados em um procedimento rápido e minimamente invasivo chamado punção ovariana, feito com sedação leve e guiado por ultrassom. A coleta dura cerca de 15 a 30 minutos e é segura, geralmente com recuperação tranquila.
Após a coleta, os óvulos passam pelo processo de vitrificação, que é um congelamento ultrarrápido por imersão em nitrogênio líquido, mantendo-os preservados por tempo indeterminado sem perder a qualidade.
Qual é a melhor idade para congelar os óvulos e por quê?
A qualidade e a quantidade dos óvulos diminuem com a idade. Portanto, o ideal é realizar o congelamento até os 35 anos, quando os óvulos são mais saudáveis e as chances de sucesso em uma futura FIV são maiores.
Além disso, óvulos mais jovens têm menor risco de alterações genéticas, o que contribui para uma gestação mais saudável. Apesar de não existir uma idade limite rígida para o congelamento, quanto antes o procedimento for realizado, melhores serão os resultados.
Mesmo para quem já passou dos 35, o congelamento pode ser uma alternativa, mas é importante estar ciente que a qualidade e quantidade dos óvulos começam a cair de forma mais acentuada a partir dessa idade.
Quais são as taxas de sucesso associadas ao uso de óvulos congelados?

As taxas de sucesso variam conforme a idade da mulher no momento do congelamento e a qualidade dos óvulos. A taxa de sobrevivência dos óvulos após o descongelamento pode chegar a 95%, e a taxa de gravidez por óvulo varia entre 2% e 12%.
Quais os riscos de congelar óvulos?
Embora seja um procedimento seguro, podem ocorrer alguns efeitos colaterais:
- Durante a estimulação ovariana: inchaço abdominal, dores de cabeça, alterações de humor e náuseas;
- Após a coleta dos óvulos: desconforto pélvico e cólicas leves;
- Raramente: síndrome de hiperestimulação ovariana, que requer acompanhamento médico.
Quantos anos os óvulos podem ficar congelados?
Os óvulos podem ser armazenados por tempo indeterminado, sem perda significativa de qualidade. No entanto, a legislação e as diretrizes médicas podem variar quanto ao tempo máximo de armazenamento.
O Conselho Federal de Medicina orienta que a mulher engravide até, no máximo, os 50 anos pelo bem-estar da gestação, mas não limita quanto tempo os óvulos podem ficar armazenados.
Quais são os custos envolvidos no congelamento de óvulos?
Em 2025, o valor total por ciclo de congelamento costuma ficar entre R$15 mil e R$30 mil. Esse valor inclui a consulta médica, os exames iniciais para avaliação da reserva ovariana, os medicamentos hormonais usados na estimulação ovariana, o acompanhamento com ultrassons e o procedimento de coleta dos óvulos, que é feito com sedação leve.
Além disso, há uma taxa anual para o armazenamento dos óvulos congelados, que geralmente varia de R$1 mil a R$2 mil, dependendo da clínica. Essa taxa é cobrada enquanto os óvulos permanecerem armazenados, sendo uma despesa recorrente que permite que os óvulos se mantenham em nitrogênio líquido, preservando sua qualidade.
Vale lembrar que a quantidade de óvulos coletados, a necessidade de mais de um ciclo e a resposta individual ao tratamento podem impactar o custo final.
Como escolher a clínica ideal para realizar o congelamento de óvulos?
Ao escolher uma clínica, considere:
- Experiência e reputação: verifique a qualificação dos profissionais e a taxa de sucesso da clínica;
- Infraestrutura: certifique-se de que a clínica possui equipamentos modernos e laboratório próprio;
- Apoio emocional: um bom suporte psicológico pode ser fundamental durante o processo;
- Transparência nos custos: confira se a clínica oferece informações claras sobre os valores envolvidos.
É possível congelar óvulos pelo SUS?
Sim, é possível congelar óvulos pelo SUS, mas com algumas restrições importantes. O procedimento é oferecido gratuitamente para mulheres que enfrentam tratamentos médicos, principalmente câncer, que podem comprometer a fertilidade, como a quimioterapia.
Nesses casos, o SUS disponibiliza o congelamento para preservar a chance da mulher engravidar no futuro. No entanto, para quem deseja congelar os óvulos por escolha pessoal, autonomia reprodutiva ou motivos não relacionados a doenças graves, o acesso pelo SUS é bastante limitado.
A procura é alta, mas o serviço público prioriza os casos oncológicos ou outras condições médicas que afetem a fertilidade. A oferta é feita em poucos centros de reprodução humana em algumas cidades brasileiras, o que pode gerar filas e espera.
O que considerar ao decidir pelo congelamento de óvulos?
Antes de tomar a decisão, é importante:
- Consultar um especialista em fertilidade: para avaliar sua saúde reprodutiva e discutir expectativas;
- Entender o processo: compreender todas as etapas, riscos e benefícios;
- Avaliar aspectos emocionais e financeiros: considerar o impacto emocional e os custos envolvidos.
Leia também: Inositol: para que serve na pré-concepção? Como ele auxilia na fertilidade e saúde hormonal.
Preserve sua fertilidade com informação e cuidado
O congelamento de óvulos é uma opção valiosa para mulheres que desejam preservar sua fertilidade e planejar a maternidade no momento mais adequado.
Compreender o processo, os benefícios e os possíveis riscos é essencial para tomar uma decisão informada.
Consultar um especialista em fertilidade é o primeiro passo para avaliar se essa é a melhor escolha para o seu caso.
As dicas não substituem consulta médica. Procure um profissional de saúde especializado para receber orientações individualizadas.


















